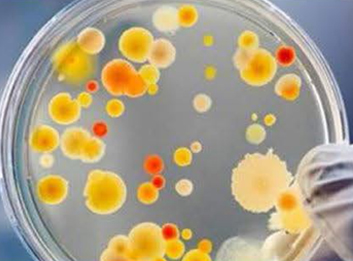
大肠杆菌

在生物实验室的日常工作中,高压均质机(也被称为高压细胞破碎机)以其独特的工作原理和高效的均质效果,成为了科研人员的重要设备。尤其是在处理如大肠杆菌等微生物时,高压均质机展现出了非凡的效能。本文将带您深入了解高压细胞破碎机如何在大肠杆菌处理中发挥作用。
高压细胞破碎机的工作原理
高压细胞破碎机,顾名思义,是一种利用高压技术实现物料均质化和细胞破碎的设备。其工作原理基于高压流体动力学原理,通过高压泵将物料加压至数千个大气压,并在极短的时间内通过狭窄的缝隙,产生强烈的剪切、撞击和空穴效应。这种的物理条件能够迅速破碎物料中的细胞、颗粒或团聚体,达到均质化的目的。

在大肠杆菌处理中的应用
大肠杆菌作为一种常见的原核生物,广泛应用于生物学、医学等领域的研究。在实验室中,科研人员经常需要对大肠杆菌进行均质处理,以便进行后续的细胞破碎、蛋白质提取等操作。高压细胞破碎机以其高效的均质效果和简便的操作流程,成为处理大肠杆菌的设备。
使用高压细胞破碎机处理大肠杆菌时,首先需要将大肠杆菌培养液进行预处理,去除其中的杂质和固体颗粒。随后,将预处理后的培养液加入高压细胞破碎机中,并设定合适的压力和均质次数。在高压和剪切力的共同作用下,大肠杆菌细胞迅速破碎,释放出细胞内的物质,为后续的实验提供了极大的便利。
高效与安全性并存
高压细胞破碎机不仅具有高效的均质化能力,还注重操作的安全性和稳定性。该设备采用的控制系统和安全保护装置,确保在实验过程中不会对实验人员造成任何伤害。同时,高压细胞破碎机还配备了温度控制系统,能够保持处理过程中物料温度的稳定,避免高温对微生物活性的破坏。
广泛的应用领域

除了在微生物处理中的表现,高压细胞破碎机在多个领域都发挥着重要作用。在生物制药领域,它被广泛用于制备纳米药物、疫苗和细胞悬液等,提高了药物的生物利用度和疗效。在食品科学领域,高压细胞破碎机用于乳化、均质化等工艺,改善了食品的口感和品质。在化工和材料科学领域,它则是制备纳米材料、高分子材料等高性能材料的得力助手。
高压细胞破碎机以其独特的工作原理和广泛的应用领域,在实验室中扮演着至关重要的角色。在处理大肠杆菌等微生物时,其高效的均质化能力和简便的操作流程,为科研人员提供了极大的便利。随着科学技术的不断进步,高压细胞破碎机将在更多领域展现出其独特的魅力和价值,为科研事业的发展贡献力量。





